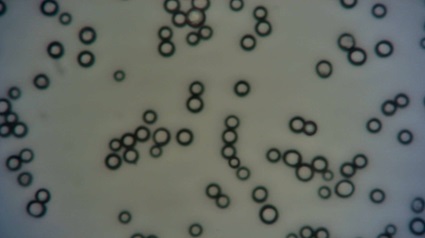

HPLC Materials
Microscopic picture of polymeric RP particles, average size is 10 µm.
Redstone Separations develops novel polymeric chromatography materials both for high pressure analytical applications, but also for semi-prep and preparative applications with eg larger particles.
Current development portfolio has the following highly cross-linked polymeric resins in the pipeline:
- DVB/Styrene reversed phase resins
- Hydrophilic polymeric resins
- Ion-Exchange resins: both strong and weak cation and anion exchangers
- Particle sizes: 10 µm, 50 µm, 70-200 µm and industrial 200-1200 µm
- Pore sizes: 100 Å, 300 Å, 500 Å, 1000 Å and >1000 Å (upon inquiry)
First prototype separations on short and longer peptides are shown below.
Example: Scanning electron microscope of 10 µm polymeric resin, porous DVB/Styrene, magnification at 25.000 x.
Below are example separations of model compounds Gly-Leu-Tyr vs Aspartame and the separation between Insulin and ACTH on a prototype Reversed Phase resin based on DVB/Styrene with 100 å or 300 Å pores.

Separation of peptides

Example separation of GLT (Gly-Leu-Tyr; 1st peak) and aspartame (Asp-Phe-OMe; 2nd peak). Conditions: Mobile phase: water, 0.1 % formic acid. 10-100 % AcN (60 min). Flow: 0.5 ml/min. Reversed Phase resin based on DVB/Styrene with 100 Å pores.

Example separation of Adrenocorticotropic hormone (ACTH; 1st peak) and Insulin (2nd peak). Conditions: Mobile phase: water, 0.1 % formic acid, 10-50 % AcN (60 mins). Flow: 0.2 ml/min. Reversed Phase resin based on DVB/Styrene with 300 Å pores.
Several of our novel RP prototypes were evaluated in a master thesis study conducted with Lund University, Sweden.
- Popular Abstract
- Introduction: Separation of bio-based compounds with therapeutic activities can be achieved on polymeric media and not only on traditional silica particles. It’s essential to identify upsides and downsides between the two material classes, such as pH range of use and mechanical tolerance, to understand which one is more suited to the specific separation mode.
Background: Current acceptable purity of some biological formulations is minimum 90% and the relative impurities can lead to side-effects, even strongly negative ones. Current traditional silica-based separation media undergo degradation at high pH, when cleaning of the stationary phase is carried out with hydroxide solutions to denature and wash away biological compounds. The most recent silica type (C) is able to withstand up to pH 11, but its cost renders it a difficult solution for scaling up production, and polymeric media may be the most satisfying solution in this regard, constituting a good middle ground between cost and performance.
Aim(s): The aim of this thesis project is to characterize styrene-divinylbenzene copolymers obtained through novel synthesis methods and their chromatographic performance in the development of separation and purification methods. This material was chosen for having a large research background already present, on which the company developed its own methods of synthesis.
Methods: Characterization of resins by light scattering, BJH analysis and optical microscope to determine particle and pore size, then test of the resins in HPLC columns with a few representative peptides to determine chromatographic performance, including column efficiency and resolution.
Results: Laser diffraction and microscope pictures are in agreement with each other and the particle size distributions are centered either at 6 or 11 µm (D50). BJH pore size analysis shows results mostly centered at around 250 Å, however a few samples have pore sizes in the 60 Å range, for both smaller and larger particles. The chromatographic gradient was optimized throughout the whole project for the resin basis, regardless of the column length and particle size, adjusting the flow for each column until a similar starting pressure was achieved. The HETP parameter was evaluated for each column, as well as the resolution of the different peaks.
Conclusion: Thanks to proprietary synthesis methods, a new series of polymeric materials were developed and, after screening, a few representative samples provided comparable results when compared to current commercial alternatives.
Pls click here to read more.
Separation of alkaloids / amines
Example of separation of alkaloids on a novel silica-coated weak cation exchanger material.

Table of properties of prototype material
Material type | Coated silica |
Particle size | 10 µm |
Pore size | 100 Å |
Surface area | 450 m2/g |
Functionality | -COOH |
Capacity | 1 mmol/g |

Example separation of organic alkaloids. Column: Prototype Temiz WCX. Flow rate: 1.5 ml/min. Eluent: H2O, AcN/FA gradient. Detection: 240 nm, Injection: caffeine, melamine, quinine mixture
Stay tuned for first products or inquire for custom-made variants. Pls contact us for suggestions or specific question or product inquiries.
We offer custom development of tailor-made resins also for HPLC materials. Please contact us for further discussion as this is a case-by-case evaluation.
Email: info@redstone-sep.com
Phone: +46-738-156-130 (Call times during CET: 8.00 – 18.00)
